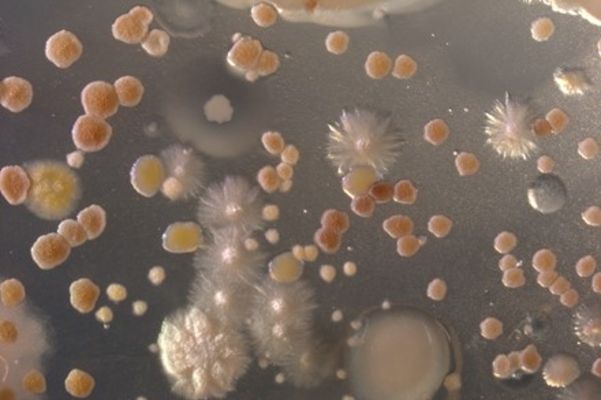

Communication through specialized metabolism
Dr Chantal Bader
Soil-dwelling (micro-)organisms have developed evolutionarily complex interaction networks with few of them characterized so far. We focus on gaining a better understanding of cross taxonomy communication in soil and its application for the discovery of unprecedented antiparasitic specialized metabolites.
Our Research and Approach
The ecological context of microorganisms is an important player for inducing specialized metabolism thereby simultaneously providing information about the natural function of the biosynthesized molecule. Microbial strain collections contain a vast amount of bacteria displaying an immense potential for the discovery of pharmaceutically relevant specialized metabolites. However, their native interaction partners in soil as key to unlock their biosynthetic machineries are mostly unknown.
Our aim is to gain insights into the ecological context of isolated soil bacteria, particularly those too rare to show up in most metagenomics analyses and currently evading toolkits for their genetic manipulation. We are focusing on discovery of novel antiparasitic and antiinfective specialized metabolites in the context of potential signaling molecules secreted by other soil microbes for their induction. Besides microbiology-based approaches, we are applying multi-omix approaches including advanced mass spectrometry workflows to identify binders to particularly interesting target proteins and determine their specificity throughout kingdoms.
Team members
Research Projects
Establishing multi-kingdom synthetic communities for high throughput screening of ecological interaction partners
Synthetic microbial communities (synComs) have emerged as valuable cultivation tool to mimic microbiomes under controlled conditions. However, current synComs developed for facilitating natural product discovery mostly apply well-established model organisms and fail to depict the taxonomic diversity in soil throughout kingdoms. To provide a screening platform for identification of interaction partners, we are working on establishing a library of diverse multi-kingdom synComs. Via entry of isolated soil bacteria into those artificial microcosms, this platform will facilitate identification of synergistic, mutual and inhibitory interactions at high throughput.
Microbial synthetic communities ©HIPS/Bader
Publications
An overview of Chantal Bader's publications can be found on her personal page.